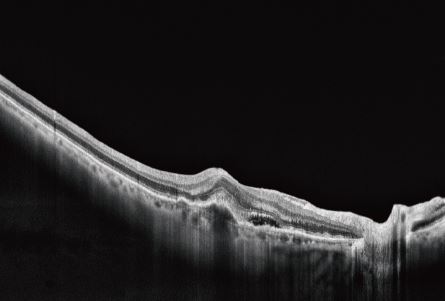

A tomografia de coerência óptica (OCT) oftálmica utilizada no BV1000S traduz-se num OCT de inteligência artificial totalmente automático com direitos de propriedade intelectual totalmente independentes. Combinado com tecnologia de registo e aperfeicoamento de imagens múltiplas e tecnologia de análise líder do setor, este OCT fornece uma solução completa para diagnóstico e tratamento clínico, incluindo captura automática, precisa e objetiva das imagens. Inclui também gestão inteligente de registo de saúde ocular e partilha de dados em tempo real na nuvem (cloud).
OCT BV1000S Totalmente automático
Description
Pedir Orçamento
Categories: Equipamentos Novos, Mobiliário